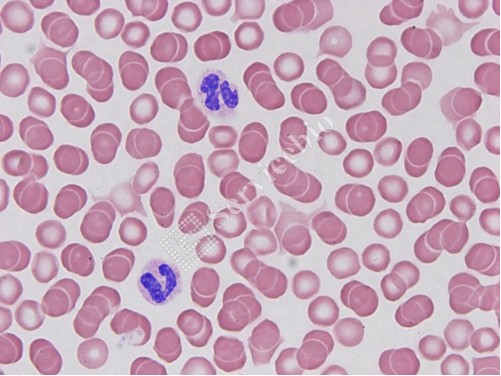

Wright-Giemsa Staining Kit | 血液(blood)和骨髓( bone marrow )塗片的染色劑貨號G1007-250ML
Wright-Giemsa 染色劑 | 血液(blood)和骨髓( bone marrow )塗片的染色劑貨號G1007-250ML 250ml+500ml
產品介紹:
賴特氏染色劑(Wright-Giemsa Staining Kit)是促進血細胞類型分化的血液染色劑。它通常是曙紅和亞甲藍染料的混合物。它主要用於對外周血塗片,尿液樣本和骨髓抽吸物進行染色,並在光學顯微鏡下進行檢查。在細胞遺傳學中,它用於染色染色體以促進綜合症和疾病的診斷。
Wright-Giemsa Stain 主要用於血液(blood)和骨髓( bone marrow )塗片的染色。 它是根據羅曼諾夫斯基染色技術(Romanowsky Stain technology)的原理進行修飾的。 細胞的染色過程是染料滲入被染物並保留在其內部的過程,既有物理吸附作用,也有化學親和作用。 由於化學性質不同,各種細胞和細胞成分對萊特-姬姆薩染色液中的酸性染料(伊紅/eosin)和鹼性染料(亞甲藍/methylene blue)的親和力不同。
本品包括兩種溶液,A液含0.2% Wright和0.1% Giemsa,B液為磷酸鹽緩衝液。 標本塗片經本品染色後,各種細胞呈不同顏色,其中紅血球細胞呈淡紅色,白細胞血漿顆粒清晰,呈現出各種細胞特有的顏色。 嗜酸性粒細胞胞質顆粒呈紫紅色,嗜鹼性粒細胞胞質顆粒呈藍色,單核細胞和淋巴細胞呈藍色。 因此,本產品可達到區分各種細胞形態特徵的目的。
Wright – Giemsa Stain is mainly used for staining blood and bone marrow smears. It is modified based on the principle of Romanowsky Stain technology. The dyeing process of cells is a process that the dye penetrates into the dyed material and remains inside it,w hich involves both physical adsorption and chemical affinity. Due to their different chemical properties, various cells and cell components have different affinities for acid dyes (eosin) and basic dyes (methylene blue) in Wright-Giemsa staining solution.
This product includes two kinds of solution , solution A contains 0.2% Wright and 0.1% Giemsa, and solution B is a phosphate buffer solution. After the specimen smear is stained with this product, various types of cells show different colors, among which the red blood cells are light red, the white blood cell plasma particles are clear, and show the unique colors of various cells. The cytoplasmic granules of eosinophils are purplish red, the cytoplasmic granules of basophils are blue, the monocytes and lymphocytes are blue. Therefore, this product can achieve the purpose of distinguishing various cell morphological characteristics.
| Component Number | Component | G1007-20ML | G1007-2 5 0ML |
| G1007-1 | Wright-Giemsa S olution A | 20 m L | 250 mL |
| G1007- 2 | Wright – Giemsa S olution B | 40 m L | 2×250 mL |
| Instruction | 1 | ||
Servicebio台灣品牌介紹-BRAND/AGENCY/品牌介紹- Servicebio



